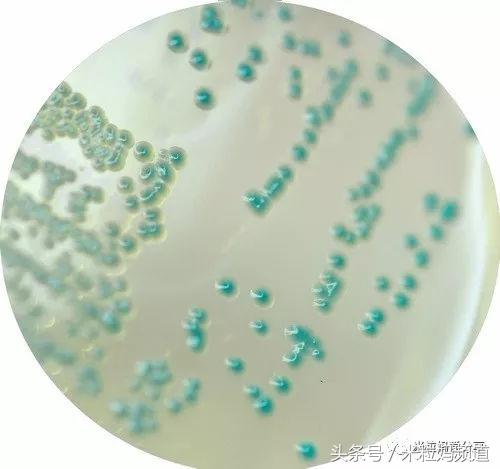
奶粉怎么样避免二次污染,婴儿奶粉受污染

文 | 米粒妈 (公众号 米粒妈爱分享)
近日多家媒体发布”爱尔兰奶粉遭污染,多国发预警”相关新闻报导表示:7月27日法国通过欧盟RASFF发出警告,爱尔兰产的婴儿奶粉疑似遭到沙门氏菌(Salmonella)污染。
米粒妈立刻上RASFF网站,第一手了解实际状况,下图是RASFF网站查询编号”2018.2152”(即此事件)的结果:

8月18日的更新资料显示:在所有后续由法国与爱尔兰的检验中,沙门氏菌的测验结果都是阴性反应,代表婴儿奶粉并没有受到沙门氏菌的污染,因此,这个事件以不成立结案。
(其实法国奶粉感染沙门氏菌很可能已经超过10年,因为同一间工厂在2005年就曾发现相同菌株。所以奶粉有没有被污染真是一点保障都没有,也很有可能不是没有污染,只是没有被检测到。)
米粒妈也在查证的同时,发现又有两个关于婴儿奶粉受到污染的警告:

都是8月17日由荷兰提出,表示荷兰产的奶粉受到葡萄球菌、真菌污染。由于事件还在调查,可能还需要几天,才会有更明确的结果报导。

不管真相如何,从去年12月婴儿奶粉大厂法国拉克塔利集团(LACTALIS)被测出含有沙门氏菌,先后全球召回1300多个批刺、共计万馀吨婴幼儿奶粉,涉及全球66个国家的事件后,所有喝奶粉宝宝的家长几乎是闻奶色变!
国产奶还没走出三聚氰胺的阴影,现在连以为很安全的海淘奶粉也出问题了。到底要买什么奶粉?什么奶粉才是安全的?成了所有奶粉宝宝家长心中最大的疑问。

国际卫生组织(WHO)与联合国农粮组织,早在2007年发表的”婴儿配方奶粉制备、储存和操作指导原则”里就表示:婴儿配方奶粉并不是无菌产品,在制造和包装过程、或是照顾者在冲冲牛奶时没有遵循正确步骤,婴儿配方奶粉都可能被沙门氏菌、阪崎肠杆菌等可能导致婴儿严重疾病的病原体污染。
目前的奶粉生产技术是无法消灭配方奶粉里面所有的细菌,这点大家一定要知晓!

沙门氏菌会造成细菌性肠胃炎、血便。而婴儿感染阪崎肠杆菌虽然少见,高发族群为:早产儿、出生体重较轻(少于2.5kg)、免疫力较差的婴儿,一旦感染,会引起新生儿脑膜炎、小肠结肠炎,死亡率高达40-80%,绝不可小觑。
阪崎肠杆菌有个特点:不怕干燥,即使在无水分的环境下,版崎肠杆菌也能生存。所以,包括WHO以及美国儿科学会不断强调、建议:
1. 调配婴儿配方奶粉时应使用不低于70℃的开水,以避免残留于奶粉中的菌体存活、生长。

2. 冲调好的婴儿配方奶应在2小时内食用完毕,若未能及时食用,应置于4℃下冷藏,冷藏时间不应超过24小时。
室温下超过2小时、冷藏超过24小时的配方奶应直接丢弃,不宜再给婴儿饮用,以避免致病菌感染。
要知道,你无法确定买的婴儿奶粉有没有问题,可是借由正确的配方乳调配方法,可以有效降低婴儿感染疾病的危险。
这是每个家长至少可以自身做到,保护自己宝宝的方法,所以不要再说孩子等不及、晚上起来很累‧‧‧‧‧‧种种理由,都是拿宝宝的健康做赌注!

米粒妈常发现很多宝爸宝妈,到处海淘最贵、口碑最好的奶粉;买很贵的奶瓶消毒器,可是对于配方奶的调配,却不是很了解,也不太在意。
于是再好的奶粉,也可能因为不懂得调配,在冲调的过程,造成奶水污染,导致宝宝生病。或是调配的浓度不对,导致宝宝营养不良或是消化道功能受到伤害。
冲冲配方奶这个看似简单的事情,需要注意的学问却不少,从"冲冲温度"到"先加水还是先加奶"、"何时需要换奶粉”等等细节,都会影响到宝宝的健康。
下面米粒妈就针对冲奶最常见的12个问题,跟大家分享正确的冲奶常识:


冲配方奶的水温要几度?
正解:标准温度70℃。
通常小婴儿饥饿哭闹时,爸妈都面临很大压力,一心只想赶快冲好奶,让宝宝喝上。所以很多人都采用40℃左右的温水来冲奶,可是这样却是让宝宝暴露在病菌的风险中。
因为,婴儿奶粉并非完全无菌,婴儿奶粉受到污染的事件时有所闻。最常见的就是沙门氏菌、李斯特菌、阪崎肠杆菌等,这些致病菌都需要高温才能被杀死。
因此,包括WHO、联合国农粮组织、美国儿科学会都表示,冲奶的标准温度为70℃、已煮沸过的开水。许多家长可能会说:”可是我买的奶粉上面就是标注用40℃泡啊!”(像X培、美X臣等)。

米粒妈在这里强调一下,我为什么建议大家用70℃水冲泡奶粉!
各家厂牌都对自己产品很有信心,基本上,在奶粉没有受到致病菌污染的情况下,是可以用40℃的温水泡。
可是!你怎么能确定每次买到的奶粉都没有受到污染呢?这从去年底到现在,各国奶粉被不同致病菌污染的新闻还嫌少吗?
此外,也有很多人会说:”阪崎肠杆菌污染现在几乎不太可能,各国都已经严格立法了,更何况虽然致死率高,但只有极少数的婴儿会因为感染致病”。
可是!就算阪崎肠杆菌的污染现在已经非常少见了,沙门氏菌污染还少吗?法国拉克塔利集团总计万余吨的婴儿奶粉不都是沙门氏菌污染了吗?
你当然可以觉得机率少,但是万一发生了,宝宝的健康就是赌注。米粒妈想每个妈妈都会宁愿自己辛苦点、多花点时间,正确地冲奶,也不想拿宝宝的健康承担奶粉厂商可能发生的污染意外吧。

70℃的配方奶当然会烫伤宝宝的嘴,因此,把奶瓶置于流动的自来水冲凉,约1分钟就可以让配方奶降到40℃左右。
如果觉得这样做很浪费水,可以把奶瓶放在装有冷水或冰水的容器中,约2分多钟,也可以冷却到适合喂哺的温度。
喂奶前应先滴几滴奶于手腕内侧测试温度,确定温度不会烫伤宝宝,再喂食。


70℃的水温会不会破坏奶粉中的营养成分?
正解:只有维生素C,或少数有添加益生菌成分的会受到影响。
研究发现,在配方奶粉常见的营养成分中,唯一会受到70℃水温影响的只有维生素C,其他成分影响不大。
因此,奶粉厂商在制造时,往往已经提高维生素C的含量,WHO的研究显示:所有测试的配方奶粉,经过70℃开水冲奶后,维生素C的含量依旧高于世界卫生组织的规范。
针对少数添加益生菌的配方奶,70℃的确会杀死益生菌。但这个问题就是面对致病菌可能带给宝宝的风险与益生菌被烫死的两个选择,身为宝宝的家长,您觉得哪个考量更为重要?米粒妈认为,没有一样营养素比宝宝的健康安全更重要了。


用矿泉水冲奶是否更佳卫生安全?
正解:错。矿泉水含有许多矿物质,对于一岁以下的新生儿来说,由于肾脏功能尚未发育成熟,吸收过多的矿物质很可能造成肾脏的负担,所以完全不建议用矿泉水冲奶。
外出游玩时,基于方便,偶尔为之还可以。但若天天都用煮沸的矿泉水冲奶,很可能对新生儿的肾脏造成伤害。


冲奶的顺序是先加水?还是先加奶粉?
正解:先加水、再加奶粉。
冲奶的顺序,关系到配方奶”量”和”浓度”。先加水、再加奶的方式,可以让奶粉比较容易均匀溶解,也比较不容易出现过多的气泡。
但是你可能会有疑问”先加水,再加入奶粉,奶量不就变多了吗?”是的!奶量变多是正确的!
例如:先加入30毫升的水,再加入一匙奶粉,最后会冲出40毫升的配方奶,代表宝宝这一餐喝的是40毫升,这样的冲泡浓度才是正确的!
尤其对于月龄越小的新生儿而言,配方奶的浓度相当重要,影响到宝宝肠胃的适应程度。
尤其有些早产儿,肠胃功能不成熟,太浓或太稀的配方奶,除了可能让宝宝拉肚子或便秘、营养不良、严重的还可能伤害肾脏功能。


宝宝太瘦小,可以用大骨汤冲奶吗?可以再配方奶中加米精或麦精吗?
正解:当然不行。老人家常喜欢以大骨汤替孩子补身体的观念需要与时俱进。大骨汤含有许多油脂,用来冲奶,因为油脂太多,会影响奶粉品质。
就算将油脂过滤掉,许多医学报告已经证实,大骨汤含有重金属成分高,给孩子喝,对孩子反而不好。
此外,在配方奶中加米精或麦精,增加宝宝的饱足感,也是不对的。主要原因为:
- 辅食的主要目的不在于吃饱,而是训练咀嚼。如果在配方奶中加入米、麦精,宝宝还是用喝的,无法达到练习口腔的咀嚼功能,只是单纯增加热量而已。
- 米精或麦精加入配方奶中,同样会造成配方奶浓度的改变,可能影响肠胃道的消化与吸收。
- 新的辅食观念中,鼓励家长使用天然食材烹调,不需特别使用米精或麦精。因为米精或麦精,多少含有人工添加物,宝宝食用后,有时反而容易造成过敏反应。如果真的要食用米、麦精,建议直接加水,冲盛一碗,以汤匙喂食。

冲奶粉如何相奶粉摇均匀才适当?正解:最好左右轻轻旋转、切忌上下摇晃。

冲奶粉时,千万不要将奶瓶上下摇晃,这样容易产生大量的气体,当宝宝将带有大量气泡的配方奶喝下肚后,就容易发生胀气。
最好的方法是,用手握住奶瓶,轻轻地左右旋转摇匀,比较不会产生气泡。


冲好的配方奶常温可以存放多久?
正解:最多不超过2小时。
配方奶因为营养丰富,是细菌滋长的最佳环境,常温下配方奶非常容易变质,家长需特别留意。冲好的配方奶如果没有喝完,超过2小时后就应直接丢弃,不要再给孩子喝了。
一般正常的进食状况下,小婴儿应该在50-60分钟内喝完一餐的奶量。因此,每餐的配方奶,最慢一小时内要喝完,如果没有喝完,剩下的建议也不要再继续让宝宝喝。
如果宝宝每次喝奶,怎样都无法在一小时内完成,又不是在厌奶期的阶段,请谘询一下小儿科医生的建议。

换奶粉要一匙一匙换,才不会适应不良拉肚子?
正解:不需要。
过去,包括卖奶粉的厂商、以及许多长辈都会说,换奶粉一定要一匙一匙慢慢换,宝宝才不会拉肚子,这样的说法其实是误解。
临床上,有些宝宝因为身体有特殊状况,经过医生评估,需要使用医疗级的特殊配方奶粉,如无乳糖的配方奶。

当使用这些特殊配方的奶粉,之后要换回一般的配方奶时,的确需要一匙一匙慢慢换,好让宝宝的肠胃适应。
如果都是一般的配方奶,只是由A厂牌换成B厂牌,直接更换即可。因为不管哪种奶粉,就像宝宝在妈妈肚子里一样都没喝过,一出生只要喝了,就有第一次,不同厂牌的同等级婴儿奶粉完全不需要一匙一匙慢慢换。
基本上,没事不要乱换奶,如果要换,就要选对目标,至于换的方式,直接换会比一匙一匙换更容易成功。毕竟不同厂牌的奶粉混在一起好不好喝呢?
可能只有喝过的宝宝才知道了。如果换奶失败,要考虑的是奶粉是不是选错了,换奶的方式反而是其次。

什么状况下,需要替宝宝换奶粉?
正解:没有特殊状况,不需要换奶粉。
一般市面上的配方奶常会分月龄,标示含不同的营养成分,但是从医学的角度而言,根本没有所谓不同月龄的”成长奶粉”这回事!
不同月龄配方奶的设计只是厂商的行销考量,因为某些国家,比如说英国,6个月以下的婴儿奶粉是不能广告的,但是6个月以上的可以。

因此,第二阶段6-12个月大的婴儿奶粉,只是为了置入广告,其实成分的规范标准,跟0-6个月的奶粉根本是一模一样的。
美国儿科学会也建议,宝宝6个月前,鼓励以母乳为优先,若妈妈的奶水不够,可以额外补充配方奶;等宝宝开始吃辅食后,饮食方式应渐渐转向以固体食物为主;到宝宝一岁,就应该可以完全吃固体食物,过程中,没有规定,一定要按时换奶。
除非孩子身体有特殊状况,在医生评估下需要喝医疗级的特殊配方奶。

1岁以后是否一定要更换成长奶粉?正解:不用。
1岁以上宝宝只要正常食物吃得好,完全不喝配方奶也行,可以完全喝鲜奶。
基本上1岁以上的宝宝应该从正餐中获得足够的营养,牛奶只是每天的营养补给,这时候的宝宝只要每餐吃正常的食物,每天搭配喝鲜奶就可以了。
鲜奶与幼儿成长奶粉到底有什么不同?根据WHO的报告,幼儿成长奶粉大部分糖分比较高,并且额外添加了很多矿物质与营养素。

糖分较高可能造成的影响是蛀牙与肥胖;很多研究也显示,多余的矿物质与营养素可能造成短期的副作用,如:便秘,或更长期的健康危害。
因此,WHO早已明文建议:零岁的婴儿配方奶可以一直喝到一岁,然后吃食物与喝鲜奶,完全不需要第二阶段或第三阶段的奶粉。

XX厂牌的奶粉可以防吐奶、便秘、肠绞痛?正解:错!
宝宝会有吐奶、便秘、肠绞痛三种症状,绝对不是换个奶粉厂牌就可以解决。这是三种不同的症状,需要请小儿科医生诊断找出疾病原因才是正解。

否则,如果是因为牛奶蛋白不适应造成的症状,换什么厂牌的奶粉,结果都是一样,因为它们的蛋白质来源,还是一样是牛奶。

羊奶、豆奶防过敏?正解:大错特错。
基本上羊奶可以预防过敏这件事,是很多羊奶厂商的广告上说:”本草纲目记载:羊奶补寒冷虚、润心肺”,然后大家就被*脑洗**了。其实”本草纲目”有很多说法早就不合时宜了,包括"小儿夜啼,猪屎烧灰,淋汁浴儿,并以少许服之”啊!!!
好了,还是回到这个问题,不管是羊奶、豆奶,都无法预防过敏,要预防过敏,先从家人戒烟开始。要想喝了什么厂牌、什么样的奶粉可以预防过敏,那是不可能的事情。
结论关于配方奶的问题,米粒妈来帮大家划重点了:首先,选择”大厂牌”的零岁婴儿奶粉,然后一路用到1岁,接着就喝鲜奶。什么是”大厂牌”呢?口碑、历史当然是考量重点,此外,产品线越完整(有早产儿配方、水解蛋白配方等),表示品牌越大,可以做完选择婴儿奶粉的指标。
选好了奶粉后,务必使用不低于70℃的开水冲冲配方奶,并且不再食用2小时内没喝完的配方奶。
这是保护宝宝健康,免于被致病菌感染的最好办法。请家长千万不要图一时的方便,伤害到宝宝的健康,毕竟新生儿常常禁不起可能的万一。

最后还是提醒大家:母乳最好,就算宝宝喝一半母乳、一半配方奶,都还是可以得到母乳的帮助,千万不要轻言放弃。而且6个月以后的母乳依然很有营养,还带有抗体,帮助体内开始失去从母体里带出来的抗体的宝宝,建立起自己的免疫系统。
所谓”靠山山倒、靠人人跑、靠自己最好”这句谚语,用在宝宝配方奶的食用安全上也非常适用。与其整天担心买到的奶粉有没有受到污染,不如正确地操作标准冲奶步骤,自己帮宝宝筑起致病菌感染的保护墙。
米粒妈碎碎念:米粒小时候,各种原因我的奶水不够,所以一半母乳一半奶粉。后来吧,每次看到奶粉出问题的新闻都很揪心,都特别羡慕全母乳妈妈……
前一段时间疫苗风波刚过,这奶粉又闹新闻,作为一个老母亲心都碎了。该怎么给孩子一个安全健康的环境啊?!看到奶粉糟污染的新闻,米粒妈赶紧查阅各种资料,给大家一个清楚的解释。
对了,关于母乳和奶粉喂养,我还写过几篇文章,戳下面链接即可跳转↓
- 这些坑娃坑娘的母乳谣言,你中了几枪?说多了全是眼泪
- 不让孩子吃母乳,你们跟孩子到底多大仇!
- 咪咪那么小,孩子奶够吃吗?史上最全母乳喂养指南来啦!
- 新生儿小肠被切,只因爸妈犯了这个错误!
- 参考文献:http://www.cdc.gov/cronobacter/technical.html
- https://www.ncbi.nlm.nih.gov/pubmed/18171262
- http://udn.com/news/story/7030/1565153
- https://mamilove.com.tw/articles/124
作者简介:@米粒妈爱分享(点击关注哦),美国海归、原500强高管麻麻一枚,专注于0-3岁宝贝的科学养育、英文和数学启蒙,以及全世界的新奇好物推荐,欢迎关注!(3-10岁宝妈请关注:@米粒妈频道)
想阅读更多精彩文章,请点击下方“了解更多”